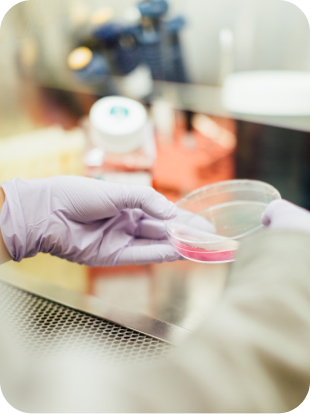
tile image

Projects
Learn about ongoing projects in the field
Discover innovative projects from experts based in Switzerland, all dedicated to advancing the understanding and treatment of neurodegenerative disorders.
Explore these projects to find potential collaborators and connect with professionals who provide key insights into the latest scientific advancements in their work.
No matching entries were found.
Please check your search query again.